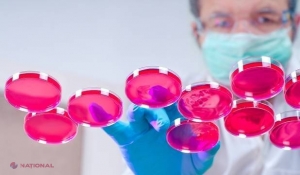
Oamenii de știință au descoperit cum pot scăpa omenirea de CANCER pancreatic

Oamenii de știință au descoperit cum pot scăpa omenirea de CANCER pancreatic
 2207
2207
Un cercetător a reuşit să transforme celulele pancreatice cancerigene în celule normale.
Prognozele pe care le primesc pacienţii care suferă de adenocarcinoame pancreatice, cea mai obişnuită formă de cancer care afectează acest organ, nu sunt tocmai optimiste. În general, medicii îi informează că mai au de trăit în jur de şase luni, scrie descopera.ro.
Cercetătorii susţin, însă, într-un nou studiu, că celulele pancreatice adenocarcinom pot fi „convinse” să se transforme înapoi în celule sănătoase, o descoperire care ar putea duce la dezvoltarea unui nou tratament.
„Pentru prima dată am arătat că expresia în exces a unei gene poate reduce potenţialul de promovare a tumorii a celulelor pancreatice adenocarcinom, dar şi să le programeze către starea iniţială a celulei”, a explicat autoarea studiului, Pamela Itkin-Ansari.
Echipa formată din oamenii de ştiinţă de la Sanford-Burnham, UC San Diego şi Universitatea Purdue a început prin a creşte celule cancerigene pancreatice în laborator, celule pe care le-au determinat să producă în cantităţi mai mari proteina E47. Aceasta este legată de o anumită secvenţă din ADN care controlează genele implicate în creştere şi diferenţiere. Rezultatul acestui experiment a fost că celulele s-au oprit din creştere şi au început să se transforme înapoi în celule normale.
Principalul motiv pentru care cancerul pancreatic este letal pentru majoritatea pacienţilor ţine de stadiul în care este descoperită boala. Simptomele, scăderea în greutate, durerile abdominale şi icterul se manifestă când tumoarea ajunge să aibă o dimensiune considerabilă, iar boala să se fi răspândit deja în organism.
 31.01.2019
10:02
31.01.2019
10:02
 3568
Descoperire uriașă // Leacul pentru cancer ar putea fi disponibil în 2020
3568
Descoperire uriașă // Leacul pentru cancer ar putea fi disponibil în 2020
 23.01.2019
18:30
23.01.2019
18:30
 2911
NEAȘTEPTAT // Drama femeii care s-a oferit șă-și ajute soțul bolnav
2911
NEAȘTEPTAT // Drama femeii care s-a oferit șă-și ajute soțul bolnav
 21.01.2019
14:02
21.01.2019
14:02
 5944
Bebelușul, născut cu o limbă uriașă, avea și o formă rară de cancer
5944
Bebelușul, născut cu o limbă uriașă, avea și o formă rară de cancer
 18.01.2019
18:04
18.01.2019
18:04
 3761
O simplă durere de burtă a unei fetițe, s-a transformat în tragedie pentru familie
3761
O simplă durere de burtă a unei fetițe, s-a transformat în tragedie pentru familie
 17.01.2019
15:02
17.01.2019
15:02
 2819
Motivul pentru care unei femei i s-a interzis sa intre în cazino
2819
Motivul pentru care unei femei i s-a interzis sa intre în cazino
 15.01.2019
11:03
15.01.2019
11:03
 5706
S-a vindecat de cancer folosind ulei de canabis
5706
S-a vindecat de cancer folosind ulei de canabis
 18.12.2018
09:02
18.12.2018
09:02
 2365
Johnson&Johnson ştia de ani de zile că pudra sa ne „îmbolnăvește” dar insistă că nu e periculoasă
2365
Johnson&Johnson ştia de ani de zile că pudra sa ne „îmbolnăvește” dar insistă că nu e periculoasă
 17.12.2018
18:05
17.12.2018
18:05
 4299
Povestea femeii care s-a PRĂBUȘIT și a RENĂSCUT din propria cenușă. Cele TREI lucruri care ne controlează viața
4299
Povestea femeii care s-a PRĂBUȘIT și a RENĂSCUT din propria cenușă. Cele TREI lucruri care ne controlează viața
 20.11.2018
11:38
20.11.2018
11:38
 2242
DESCOPERIRE // Un nou test de sânge i-ar putea scuti pe pacienţii cu cancer de o chimioterapie inutilă
2242
DESCOPERIRE // Un nou test de sânge i-ar putea scuti pe pacienţii cu cancer de o chimioterapie inutilă
 30.10.2018
19:40
30.10.2018
19:40
 7322
Un rus susține că a DESCOPERIT tratamentul pentru cancer. Care este rețeta
7322
Un rus susține că a DESCOPERIT tratamentul pentru cancer. Care este rețeta
 08.10.2018
14:39
08.10.2018
14:39
 2262
Aparatul care poate depista cancerul în doar DOUĂ ore a ajuns în România. Cât costă această investigație?
2262
Aparatul care poate depista cancerul în doar DOUĂ ore a ajuns în România. Cât costă această investigație?
 04.10.2018
18:04
04.10.2018
18:04
 2179
Fostă Miss Anglia refuză chimioterapia și vrea să își trateze cancerul cu cannabis
2179
Fostă Miss Anglia refuză chimioterapia și vrea să își trateze cancerul cu cannabis
 25.11.2025
12:17
25.11.2025
12:17
 4
ULTIMA ORĂ // Trimisul lui Putin la Chișinău, convocat la MAE în legătură cu PRĂBUȘIREA unei drone la Cuhureștii de Jos, raionul Florești
4
ULTIMA ORĂ // Trimisul lui Putin la Chișinău, convocat la MAE în legătură cu PRĂBUȘIREA unei drone la Cuhureștii de Jos, raionul Florești
 25.11.2025
12:08
25.11.2025
12:08
 114
Macron clarifică: Franța nu va trimite tinerii să lupte în Ucraina, deși subliniază nevoia de consolidare a legăturii armată-națiune
114
Macron clarifică: Franța nu va trimite tinerii să lupte în Ucraina, deși subliniază nevoia de consolidare a legăturii armată-națiune
 25.11.2025
12:01
25.11.2025
12:01
 108
ULTIMA ORĂ // Dodon și Victoria Furtună au dat VERDICTUL în privința dronei căzute pe o casă din raionul Florești: „A fost așezată pe acoperiș… Cum poate o dronă cu EXPLOZIBIL să aterizeze pe ardezie fără niciun fel de distrugere?”
108
ULTIMA ORĂ // Dodon și Victoria Furtună au dat VERDICTUL în privința dronei căzute pe o casă din raionul Florești: „A fost așezată pe acoperiș… Cum poate o dronă cu EXPLOZIBIL să aterizeze pe ardezie fără niciun fel de distrugere?”
 25.11.2025
11:56
25.11.2025
11:56
 150
13.500 de studenți învață despre integritatea academică într-o campanie națională ambițioasă
150
13.500 de studenți învață despre integritatea academică într-o campanie națională ambițioasă
 25.11.2025
10:54
25.11.2025
10:54
 287
Eugeniu Osmochescu promovează la UNIDO modernizarea industrială și tranziția către energia verde în Republica Moldova
287
Eugeniu Osmochescu promovează la UNIDO modernizarea industrială și tranziția către energia verde în Republica Moldova
 25.11.2025
10:27
25.11.2025
10:27
 259
Societatea civilă participă activ în licitațiile pentru producerea energiei verzi în Moldova
259
Societatea civilă participă activ în licitațiile pentru producerea energiei verzi în Moldova
 25.11.2025
10:10
25.11.2025
10:10
 392
Dronele armatei lui Putin ÎNCALCĂ flagrant spațiul aerian al R. Moldova. ȘASE aparate de zbor au fost detectate astăzi în Dondușeni, Orhei, Tighina, Vadul lui Vădă și Florești
392
Dronele armatei lui Putin ÎNCALCĂ flagrant spațiul aerian al R. Moldova. ȘASE aparate de zbor au fost detectate astăzi în Dondușeni, Orhei, Tighina, Vadul lui Vădă și Florești
 25.11.2025
09:59
25.11.2025
09:59
 515
FOTO // O dronă rusească, cu însemnul „Z”, a căzut pe ACOPERIȘUL unei construcții din localitatea Cuhureștii de Jos, raionul Florești,
515
FOTO // O dronă rusească, cu însemnul „Z”, a căzut pe ACOPERIȘUL unei construcții din localitatea Cuhureștii de Jos, raionul Florești,
 25.11.2025
08:14
25.11.2025
08:14
 401
Horoscopul zilei 25.11.2025
401
Horoscopul zilei 25.11.2025
 25.11.2025
07:07
25.11.2025
07:07
 376
Kiev sub atac: întreruperi de curent și apă în urma bombardamentelor rusești, o clădire avariată în districtul Dnipro și victime umane
376
Kiev sub atac: întreruperi de curent și apă în urma bombardamentelor rusești, o clădire avariată în districtul Dnipro și victime umane
 25.11.2025
06:35
25.11.2025
06:35
 578
Presiuni americane asupra Ucrainei la negocierile din Geneva, dezvăluiri ale unui oficial
578
Presiuni americane asupra Ucrainei la negocierile din Geneva, dezvăluiri ale unui oficial
 25.11.2025
04:52
25.11.2025
04:52
 511
Casa Albă confirmă: nicio întâlnire Zelenski-Trump săptămâna aceasta, dar speranțe pentru un acord de pace în Ucraina
511
Casa Albă confirmă: nicio întâlnire Zelenski-Trump săptămâna aceasta, dar speranțe pentru un acord de pace în Ucraina
 25.11.2025
04:09
25.11.2025
04:09
 444
Șantierul Naval Damen În Fața Justiției: Acuzații de Încălcare a Sancțiunilor și Corupție în Olanda
444
Șantierul Naval Damen În Fața Justiției: Acuzații de Încălcare a Sancțiunilor și Corupție în Olanda
 25.11.2025
04:04
25.11.2025
04:04
 451
Kiev sub atac: explozii nocturne și apărare aeriană activată în întreaga Ucraină
451
Kiev sub atac: explozii nocturne și apărare aeriană activată în întreaga Ucraină
 25.11.2025
02:08
25.11.2025
02:08
 514
Zelenski pregătește discuții directe cu Trump privind planul de pace pentru Ucraina, avertizând asupra intențiilor Rusiei de a sabota procesul
514
Zelenski pregătește discuții directe cu Trump privind planul de pace pentru Ucraina, avertizând asupra intențiilor Rusiei de a sabota procesul
 24.11.2025
21:03
24.11.2025
21:03
 717
Ucraina revoluționează comunicarea mobilă cu lansarea serviciului Starlink direct-to-cell în Europa
717
Ucraina revoluționează comunicarea mobilă cu lansarea serviciului Starlink direct-to-cell în Europa
 24.11.2025
20:39
24.11.2025
20:39
 898
Schimbări de temperatură semnificative în Moldova pe 25 noiembrie 2025
898
Schimbări de temperatură semnificative în Moldova pe 25 noiembrie 2025
 24.11.2025
20:17
24.11.2025
20:17
 731
Kremlinul preferă planul de pace al lui Trump în detrimentul soluțiilor europene pentru Ucraina
731
Kremlinul preferă planul de pace al lui Trump în detrimentul soluțiilor europene pentru Ucraina
 24.11.2025
18:33
24.11.2025
18:33
 611
UNICEF și USMF lansează ghidul și platforma pentru intervenția timpurie în copilărie, sprijinind dezvoltarea armonioasă a celor mici în Moldova
611
UNICEF și USMF lansează ghidul și platforma pentru intervenția timpurie în copilărie, sprijinind dezvoltarea armonioasă a celor mici în Moldova
 24.11.2025
18:01
24.11.2025
18:01
 765
Merz solicită implicarea Rusiei în negocierile pentru pacea din Ucraina, în timp ce Trump și Putin par optimiști după discuțiile de la Geneva.
765
Merz solicită implicarea Rusiei în negocierile pentru pacea din Ucraina, în timp ce Trump și Putin par optimiști după discuțiile de la Geneva.
 24.11.2025
17:54
24.11.2025
17:54
 550
Teatrul de Păpuși „Licurici” unește peste 300 de copii, inclusiv refugiați, prin activități de coeziune socială
550
Teatrul de Păpuși „Licurici” unește peste 300 de copii, inclusiv refugiați, prin activități de coeziune socială
 24.11.2025
17:35
24.11.2025
17:35
 594
Polonia investighează un nou suspect ucrainean în cazul sabotajului feroviar atribuit Rusiei
594
Polonia investighează un nou suspect ucrainean în cazul sabotajului feroviar atribuit Rusiei
 24.11.2025
17:23
24.11.2025
17:23
 542
Bani pentru fermieri: AIPA distribuie 470 mii lei, iar Guvernul 13,91 milioane pentru daunele provocate de fenomene meteo extreme
542
Bani pentru fermieri: AIPA distribuie 470 mii lei, iar Guvernul 13,91 milioane pentru daunele provocate de fenomene meteo extreme
 24.11.2025
16:29
24.11.2025
16:29
 1066
Probleme mari pentru socialistul Igor Dodon? Dosarul „kuliok” va fi reluat de la ZERO. Procurorii EXPLICĂ ce se va întâmpla mai departe, iar Dodon iese la CONTRAATAC
1066
Probleme mari pentru socialistul Igor Dodon? Dosarul „kuliok” va fi reluat de la ZERO. Procurorii EXPLICĂ ce se va întâmpla mai departe, iar Dodon iese la CONTRAATAC
 24.11.2025
15:50
24.11.2025
15:50
 618
Elevii refugiați din Ucraina primesc sprijin lingvistic la Gimnaziul „Dimitrie Cantemir” din Ștefan Vodă
618
Elevii refugiați din Ucraina primesc sprijin lingvistic la Gimnaziul „Dimitrie Cantemir” din Ștefan Vodă
 ULTIMA ORĂ // Trimisul lui Putin la Chișinău, convocat la MAE în legătură cu PRĂBUȘIREA unei drone la Cuhureștii de Jos, raionul Florești
ULTIMA ORĂ // Trimisul lui Putin la Chișinău, convocat la MAE în legătură cu PRĂBUȘIREA unei drone la Cuhureștii de Jos, raionul Florești
 Macron clarifică: Franța nu va trimite tinerii să lupte în Ucraina, deși subliniază nevoia de consolidare a legăturii armată-națiune
Macron clarifică: Franța nu va trimite tinerii să lupte în Ucraina, deși subliniază nevoia de consolidare a legăturii armată-națiune
 ULTIMA ORĂ // Dodon și Victoria Furtună au dat VERDICTUL în privința dronei căzute pe o casă din raionul Florești: „A fost așezată pe acoperiș… Cum poate o dronă cu EXPLOZIBIL să aterizeze pe ardezie fără niciun fel de distrugere?”
ULTIMA ORĂ // Dodon și Victoria Furtună au dat VERDICTUL în privința dronei căzute pe o casă din raionul Florești: „A fost așezată pe acoperiș… Cum poate o dronă cu EXPLOZIBIL să aterizeze pe ardezie fără niciun fel de distrugere?”
 13.500 de studenți învață despre integritatea academică într-o campanie națională ambițioasă
13.500 de studenți învață despre integritatea academică într-o campanie națională ambițioasă
 1 MDL
1 MDL
 1 EUR
19.83
1 EUR
19.83
 1 USD
17.17
1 USD
17.17
 1 RON
3.90
1 RON
3.90
 1 RUB
0.22
1 RUB
0.22
 1 UAH
0.40
1 UAH
0.40











 Inapoi
Inapoi




















